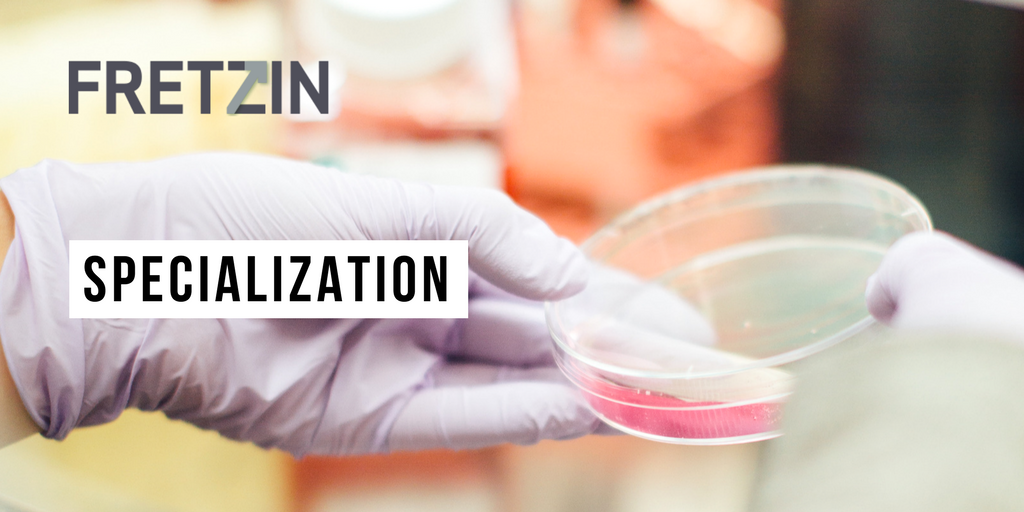
stevefretzin's tweet image. Specialization to More Efficiently Grow Your Law Practice linkedin.com/pulse/speciali… #legalbusinessdevelopment #fretzin #attorneycoach

#legalbusinessdevelopment نتائج البحث
What if you could grow your law practice without feeling "salesy" or pushy? 🤔 In this week's episode, Steve Fretzin shares a revolutionary approach that resonates with the legal community, leading to incredible results. Get ready for a game-changer! #LegalBusinessDevelopment
Why do lawyers lose control in client meetings? Click the bio link to watch the full episode. bio.link/stevefretzin #AttorneyCoaching #LegalBusinessDevelopment #SalesFreeSelling #LawFirmSuccess #LawyerTips

Do lawyers really hate selling? Click the bio link to watch the full episode. bio.link/stevefretzin #Lawyers #LegalBusinessDevelopment #AttorneyMarketing #SalesFreeSelling #LawFirmGrowth

Why do so many lawyers waste hours on maybes? Click the bio link to watch the full episode. bio.link/stevefretzin #LawyerTips #LegalBusinessDevelopment #SalesFreeSelling #LawFirmSuccess #BusinessDevelopment

🎙️ Sneak Peek: Scott Simmons on Mastering Legal Business Development 📺 Click below to watch: 🔗 youtu.be/R03OlVTZJ8I Let me know your biggest takeaway in the comments! #BeThatLawyer #LegalBusinessDevelopment #LawFirmSuccess
So humbled and grateful to be celebrating 15 YEARS in business today. A big THANK YOU to all of my clients and supporters who make my life so fun and rewarding! . . . . . #stevefretzin #legalbusinessdevelopment #bethatlawyer #legalmarketing

Just a quick thank you to the terrific attorneys at MPSLAW for having me as their guest speaker yesterday. And thanks to Max Guggenheim for wearing the same shirt I was!! #mpslaw #lawfirmspeaker #legalbusinessdevelopment #cle #attorneys #lawyers #ambitiousattorney

Are you overwhelmed with how to grow your law practice? Click the bio link to watch the full episode. bio.link/stevefretzin #LawyerGrowth #LawPracticeManagement #LegalBusinessDevelopment

This is what we do. FRETZIN helps you "BE THAT LAWYER." ow.ly/5kWs50v1utA #bethatlawyer #legalbusinessdevelopment #attorney #lawyer

Is your business development strategy getting the results you want? Click the bio link to watch the full episode. bio.link/stevefretzin #LegalBusinessDevelopment #LawFirmGrowth #LawyerTips

Our clients say it best: FRETZIN can help you transform your law practice. Call today to find out how. #bethatlawyer #legalbusinessdevelopment #lawfirms #attorney #lawyer #testimonial #colleenhurley #lavelllaw ow.ly/v4a150veGgW

Announcing the premiere of our new series on ASBN called Launched & Legal with Dayna Thomas, Esq., entrepreneurship attorney, and law firm coach. Tune to myASBN.com next Tuesday 1/18! - @daynathomaslaw #legalbusinessdevelopment #startupbusiness #trademarkattorney
"As you know, in my bestselling book – “The Attention switch” I explain at length the power of giving genuine attention in building relationships with your connections. So, let's connect it now to #legalbusinessdevelopment... read more" lttr.ai/xYLA #law

Prepare your #attorneys for 2019. Get them into a workshop to introduce new skills, tools & strategies to jump start your firm's BD. #LegalBusinessDevelopment 2020lead.com/solutions/work…

Interview Amira Irfan Founder A Self Guru - How To Scale Your Legal Business The key is to never give up and remember that it’s all part of the learning process @ASelfGuru gallantceo.com/blog/2023/02/1… #legalbusinessdevelopment #aselfguru #legalbusiness #succesfulwomen

Join me for a free online session where I’ll share insights on the essential foundations you need to implement for lasting success. Don’t miss out on this opportunity to kickstart your firm’s growth. insideoutimage.co.uk/articles/key-f… #LawFirmGrowth #LegalBusinessDevelopment

"Nobody goes into a sport, professional sport, without a plan. Now, it doesn't always work. But they have a plan" @stevefretzin talks #legalbusinessdevelopment on #The1958Lawyer #podcast | bit.ly/397JVlk #law #lawyer #lawfirm

بعد فترة من التوقف، أعود برؤية أعمق ورسالة أوضح. لم يكن الغياب فراغًا، بل انشغالًا بتأسيس BAZAD Law Firm وتطبيق عملي لأفكار تطوير المكاتب القانونية. قريبًا أشارك سلسلة منشورات عملية لأصحاب المكاتب الطموحة. #تطوير_مكاتب_المحاماة #BAZAD #LegalBusinessDevelopment

Unlock the Secrets to Developing Business as a Lawyer! Discover effective strategies to attract and retain clients in the legal field. Read now and pave the way to a thriving legal career. mtr.cool/ubmifuwlce #LegalBusinessDevelopment #ClientAcquisition #LawyerTips

Is your law firm thriving, or just surviving? Click the bio link to watch the full episode. bio.link/stevefretzin #LawFirmGrowth, #LawPracticeManagement #LegalBusinessDevelopment

Why do lawyers lose control in client meetings? Click the bio link to watch the full episode. bio.link/stevefretzin #AttorneyCoaching #LegalBusinessDevelopment #SalesFreeSelling #LawFirmSuccess #LawyerTips

Why do so many lawyers waste hours on maybes? Click the bio link to watch the full episode. bio.link/stevefretzin #LawyerTips #LegalBusinessDevelopment #SalesFreeSelling #LawFirmSuccess #BusinessDevelopment

Do lawyers really hate selling? Click the bio link to watch the full episode. bio.link/stevefretzin #Lawyers #LegalBusinessDevelopment #AttorneyMarketing #SalesFreeSelling #LawFirmGrowth

Are you overwhelmed with how to grow your law practice? Click the bio link to watch the full episode. bio.link/stevefretzin #LawyerGrowth #LawPracticeManagement #LegalBusinessDevelopment

Is your business development strategy getting the results you want? Click the bio link to watch the full episode. bio.link/stevefretzin #LegalBusinessDevelopment #LawFirmGrowth #LawyerTips

Is your law firm thriving, or just surviving? Click the bio link to watch the full episode. bio.link/stevefretzin #LawFirmGrowth, #LawPracticeManagement #LegalBusinessDevelopment

Are you still waiting for referrals to grow your business? Click the bio link to watch the full episode. bio.link/stevefretzin #ClientAttraction #LegalBusinessDevelopment #LawPractice

Are you struggling to attract clients to your law practice? Click the bio link to watch the full episode. bio.link/stevefretzin #Lawyers #LawPractice #LegalBusinessDevelopment

بعد فترة من التوقف، أعود برؤية أعمق ورسالة أوضح. لم يكن الغياب فراغًا، بل انشغالًا بتأسيس BAZAD Law Firm وتطبيق عملي لأفكار تطوير المكاتب القانونية. قريبًا أشارك سلسلة منشورات عملية لأصحاب المكاتب الطموحة. #تطوير_مكاتب_المحاماة #BAZAD #LegalBusinessDevelopment

🎙️ Sneak Peek: Scott Simmons on Mastering Legal Business Development 📺 Click below to watch: 🔗 youtu.be/R03OlVTZJ8I Let me know your biggest takeaway in the comments! #BeThatLawyer #LegalBusinessDevelopment #LawFirmSuccess
Join me for a free online session where I’ll share insights on the essential foundations you need to implement for lasting success. Don’t miss out on this opportunity to kickstart your firm’s growth. insideoutimage.co.uk/articles/key-f… #LawFirmGrowth #LegalBusinessDevelopment

Unlock the Secrets to Developing Business as a Lawyer! Discover effective strategies to attract and retain clients in the legal field. Read now and pave the way to a thriving legal career. mtr.cool/ubmifuwlce #LegalBusinessDevelopment #ClientAcquisition #LawyerTips

What if you could grow your law practice without feeling "salesy" or pushy? 🤔 In this week's episode, Steve Fretzin shares a revolutionary approach that resonates with the legal community, leading to incredible results. Get ready for a game-changer! #LegalBusinessDevelopment
Interview Amira Irfan Founder A Self Guru - How To Scale Your Legal Business The key is to never give up and remember that it’s all part of the learning process @ASelfGuru gallantceo.com/blog/2023/02/1… #legalbusinessdevelopment #aselfguru #legalbusiness #succesfulwomen

I enjoyed shooting new video content yesterday with our marketing director, Barry Zlotowicz, for the FRETZIN website and our upcoming corporate re-branding. Stay tuned- very excited to share these with you soon! #bethatlawyer #legalmarketing #legalbusinessdevelopment


Is growing your business on your list of goals for 2019? Fretzin, Inc. can help you achieve that. #Fretzin #legalbusinessdevelopment #2019goals #legalnetworking #legalnetworking

Why do lawyers lose control in client meetings? Click the bio link to watch the full episode. bio.link/stevefretzin #AttorneyCoaching #LegalBusinessDevelopment #SalesFreeSelling #LawFirmSuccess #LawyerTips

Do lawyers really hate selling? Click the bio link to watch the full episode. bio.link/stevefretzin #Lawyers #LegalBusinessDevelopment #AttorneyMarketing #SalesFreeSelling #LawFirmGrowth

A question for my followers as you start your week: what's a new challenge your law firm has encountered in 2019? Comment below and let's discuss. #legalbusinessdevelopment #lawfirms #attorney #lawyer #legalmarketing

So humbled and grateful to be celebrating 15 YEARS in business today. A big THANK YOU to all of my clients and supporters who make my life so fun and rewarding! . . . . . #stevefretzin #legalbusinessdevelopment #bethatlawyer #legalmarketing

Just a quick thank you to the terrific attorneys at MPSLAW for having me as their guest speaker yesterday. And thanks to Max Guggenheim for wearing the same shirt I was!! #mpslaw #lawfirmspeaker #legalbusinessdevelopment #cle #attorneys #lawyers #ambitiousattorney

Testimonial Thursday: Attorneys have questions about what FRETZIN can do for them. Hearing from our clients is the best way we can answer that. Thank you Phillip, for the endorsement. #testimonial #endorsement #legalbusinessdevelopment

Why do so many lawyers waste hours on maybes? Click the bio link to watch the full episode. bio.link/stevefretzin #LawyerTips #LegalBusinessDevelopment #SalesFreeSelling #LawFirmSuccess #BusinessDevelopment

Pinch Punch First Day of the Month. Focusing on #InternationalCoffeeDay today whilst working hard for amazing clients. #legalwriting #legalbusinessdevelopment @emplawuk
Are you overwhelmed with how to grow your law practice? Click the bio link to watch the full episode. bio.link/stevefretzin #LawyerGrowth #LawPracticeManagement #LegalBusinessDevelopment

This is what we do. FRETZIN helps you "BE THAT LAWYER." ow.ly/5kWs50v1utA #bethatlawyer #legalbusinessdevelopment #attorney #lawyer

Specialization to More Efficiently Grow Your Law Practice linkedin.com/pulse/speciali… #legalbusinessdevelopment #fretzin #attorneycoach
The first draft of my new book is here! Working on finalizing "The Ambitious Attorney" and feeling excited to get this out to you all very soon. Be sure to pre-order your copy today at 50% off here: ow.ly/k1pI50qsgj7 #lawyermarketing #legalbusinessdevelopment

Is your business development strategy getting the results you want? Click the bio link to watch the full episode. bio.link/stevefretzin #LegalBusinessDevelopment #LawFirmGrowth #LawyerTips

Interview Amira Irfan Founder A Self Guru - How To Scale Your Legal Business The key is to never give up and remember that it’s all part of the learning process @ASelfGuru gallantceo.com/blog/2023/02/1… #legalbusinessdevelopment #aselfguru #legalbusiness #succesfulwomen

Our clients say it best: FRETZIN can help you transform your law practice. Call today to find out how. #bethatlawyer #legalbusinessdevelopment #lawfirms #attorney #lawyer #testimonial #colleenhurley #lavelllaw ow.ly/v4a150veGgW

It's Official! Fretzin Now Offers a Marketing and Business Development Partnership. Learn more about our #legalmarketing and #legalbusinessdevelopment service to help grow your #law firm here: s.einnews.com/m6bgMeoaue

Is your law firm thriving, or just surviving? Click the bio link to watch the full episode. bio.link/stevefretzin #LawFirmGrowth, #LawPracticeManagement #LegalBusinessDevelopment

Something went wrong.
Something went wrong.
United States Trends
- 1. #TheGamingAwards N/A
- 2. Good Thursday 30.9K posts
- 3. #ThursdayThoughts 1,868 posts
- 4. #WeekndTourLeaks N/A
- 5. #thursdaymotivation 1,930 posts
- 6. #TikTokCouplesAreFake N/A
- 7. Happy Friday Eve N/A
- 8. FAYE SHINE IN ARMANI 149K posts
- 9. Nnamdi Kanu 76.7K posts
- 10. Crockett 62.2K posts
- 11. FEMA 86.3K posts
- 12. Ray Dalio 1,235 posts
- 13. LINGORM CH3 CALENDAR SIGN 864K posts
- 14. FREE HAT 2,073 posts
- 15. The 2024 87.7K posts
- 16. Wordle 1,615 X N/A
- 17. The 1990 7,605 posts
- 18. The CDC 13.4K posts
- 19. NO CAP 14.7K posts
- 20. But Jesus 22.1K posts












